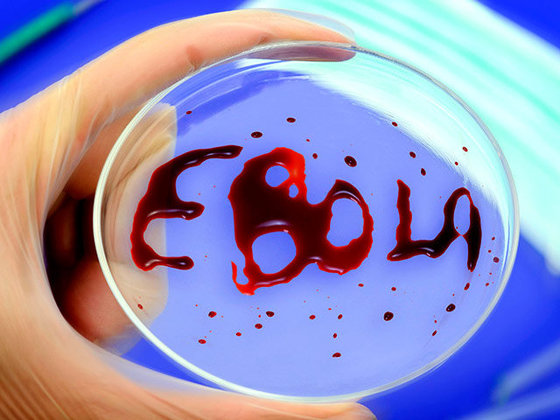

Александр Стародубов | "Слава прабабушек томных, Домики старой Москвы."-М.Цветаева. ...
Календула--солнечный цветок - (0)Календула--солнечный цветок ...
Витиеватость Словаря русских анти-пословиц - (0). Словарь русских анти-пословиц. > В Германии существует Грайфсвальдский университет, од...
Восхитительное цветение имбиря - (2)Так цветет имбирь Цветение имбиря – очень редкое явление для России и Европы, но если соблюдать в...
Ах, эти дирижеры симфонических оркестров!!! Фразы! Убийственный юмор!! - (0)УБИЙСТВЕННЫЙ ЮМОР! ФРАЗЫ ДИРИЖЕРОВ СИМФОНИЧЕСКИХ ОРКЕСТРОВ. Остались вс...
РУКОПИСИ НЕ ГОРЯТ
Что Америка скрывает об Эболе. Пора паниковать? |
|
|
Медики британской «скорой» выбросили труп на помойку |
В городе Или в восточной Великобритании работники скорой помощи, чтобы поскорее закончить смену, отделались от трупа пациента.
|
|
Древняя кухня |
|
|
Вариант маникюра для Хеллоуина... |
|
|
Бомж со свалки: "Как, я съел собаку?!" |
Буквально вчера в социальной сети "ВКонтакте" появилось сообщение от волонтёра мини-приюта для животных Галины Великосельской, что на улице Тухачевского, прямо на свалке за гипермаркетом детских товаров RICH FAMILY, обитает мужчина без определённого места жительства, который издевается над собаками. И якобы даже ест их. Фотографии с замученными (но живыми) четвероногими прилагались.
Корреспонденты Vsё42 – как люди, неравнодушные к животным, – не смогли пройти мимо и не разобраться подробнее в этой ситуации. Для этого мы и связались с волонтёрами, и наведались в гости к самому "собакоеду".
Версия номер один
|
|
Свидание с малолетней из соцсети для мужчины обернулось неприятным сюрпризом |
12 октября 2014 года, 22-летний житель Санкт-Петербурга познакомился с девушкой в социальной сети «ВКонтакте». На ее странице было указано, что ее зовут Катя. Пообщавшись в интернете, молодые люди созвонились и договорились о встрече. На следующий день парень подъехал на автомобиле «Фольксваген Джетта» своего друга из Новгородской области к дому 10/1 по проспекту Непокоренных.
Как сообщает АН «Оперативное прикрытие», девушки на месте не было. Вместо нее в авто
|
|
Правительство решило ужесточить наказание для неплательщиков алиментов |
В правительстве подготовлен законопроект, ужесточающий наказание для злостных неплательщиков алиментов, сообщила вице-премьер Ольга Голодец.
|
|
Портал в параллельный мирЪ |
|
|